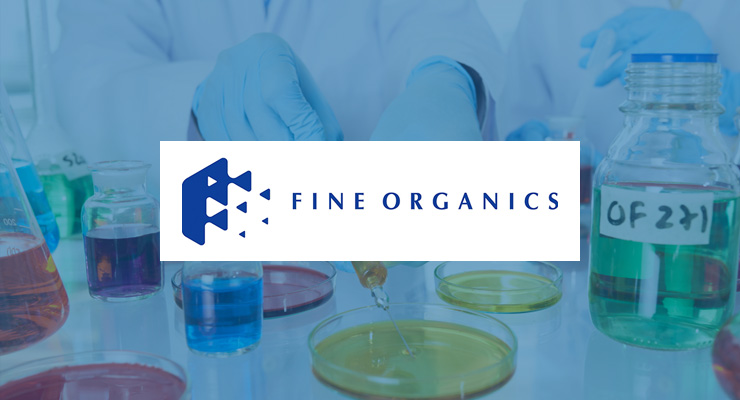
post-title

Fine Organic Industries
Today, we shine the spotlight on Fine Organic Industries Limited, a prominent player in the production of oleo-chemical based additives in India and globally. These additives are essential for various industries, including food, polymer, and specialty applications. Fine Organic Industries stands out due to its commitment to high quality, consistency, customization, safety, and environmental considerations, which create significant barriers to entry.
The company’s competitive advantages are further supported by its strong research and development capabilities and customer-centric approach. Fine Organic Industries is also well-positioned to benefit from the growing demand for green additives. However, it faces risks related to regulations, customer actions, and volatility in raw material prices.
Company Overview:
Fine Organic Industries Limited was founded in 1970 as a partnership firm by Ramesh Shah and Prakash Kamat. Initially, the company aimed to replace imported emulsifiers for ice cream makers and bakeries in Mumbai. Over the past five decades, Fine Organic Industries has expanded its additive product portfolio across various applications and established a strong customer base in India and export markets.
Today, it is the largest producer of oleo-chemical based additives in India and a significant player globally. With a wide range of over 400 products, Fine serves more than 750 direct customers and operates through 170 distributors across 70 countries. In FY20, exports accounted for approximately 55% of the company’s revenues.
The company’s additives are derived from vegetable oils, such as palm oil, palm kernel oil, castor oil, rice bran oil, and sunflower oil. Additives play a vital role in various industries, and Fine Organic Industries has a particularly strong presence in the food and polymer segments, which contribute to a significant portion of its revenues.

Financial Performance:
Fine Organic Industries has demonstrated stable and healthy financial performance over the past 3, 5, and 7 years, with strong double-digit growth in EBITDA. The company’s operating margins have expanded due to scale benefits, an improved product mix, and stable raw material prices. Fine Organic Industries maintains one of the best fixed asset turnovers in the specialty chemicals space, indicating efficient utilization of its assets. Despite facing margin headwinds in FY21, primarily due to rising raw material prices, the company has managed to maintain a healthy and stable return on capital employed (RoCE).

Key Success Factors for Fine Organic Industries:
Entry Barriers and Stringent Approval Process:
Fine Organic Industries benefits from high entry barriers, such as the critical role additives play in the end products and the need for consistent quality across different batches. The company’s focus on customized additives tailored to meet specific customer requirements creates additional barriers. The development process involves close collaboration between the customer and Fine’s product development team, necessitating a high level of trust between the parties. These factors make it challenging for new entrants to replicate Fine’s expertise and relationships with customers.
Strong Research and Development:
Fine Organic Industries prioritizes innovation and has built a robust R&D team that has played a crucial role in the company’s growth. The team focuses on product development, technical support, and process improvements. The company has successfully introduced oleochemical-based alternatives for crude oil or animal fat-based additives, offering safer options for various industries. Fine’s in-house engineering team also contributes to cost-effective plant design and fabrication, facilitating the company’s expansion into new products.
Growing Demand for Green Additives:
Fine Organic Industries benefits from the increasing global preference for green additives derived from plant sources. These additives are safer and more environmentally friendly compared to synthetic alternatives. As a leader in the production of oleo-chemical based additives, Fine is well-positioned to capitalize on this trend and expects continued demand across industries without compromising on performance.
Key Risks:
Regulations and Customer Actions:
Any regulatory changes or actions related to products, production processes, or quality requirements can disrupt Fine Organic Industries’ business. Additionally, stringent demands from customers or regulatory bodies may pose challenges. The company’s operations could be affected by unforeseen regulatory interventions, as demonstrated by the show cause notice issued by the Maharashtra Pollution Control Board in 2020, which temporarily impacted Fine’s manufacturing operations.
Volatility in Raw Material Prices:
Sharp fluctuations in raw material prices can impact Fine Organic Industries’ margins in the short term. Mismatches in the duration and timing of contracts with vendors and customers may expose the company to cost inflation risks. Global supply chain exposure and government-imposed duties on key raw materials also contribute to uncertainties in raw material prices. Fine’s ability to manage these risks by renewing contracts based on prevailing raw material prices will be crucial going forward.
Disclaimer: The views expressed in this blog are for educational purposes only. This is not professional advice. Consult your financial advisor before investing.